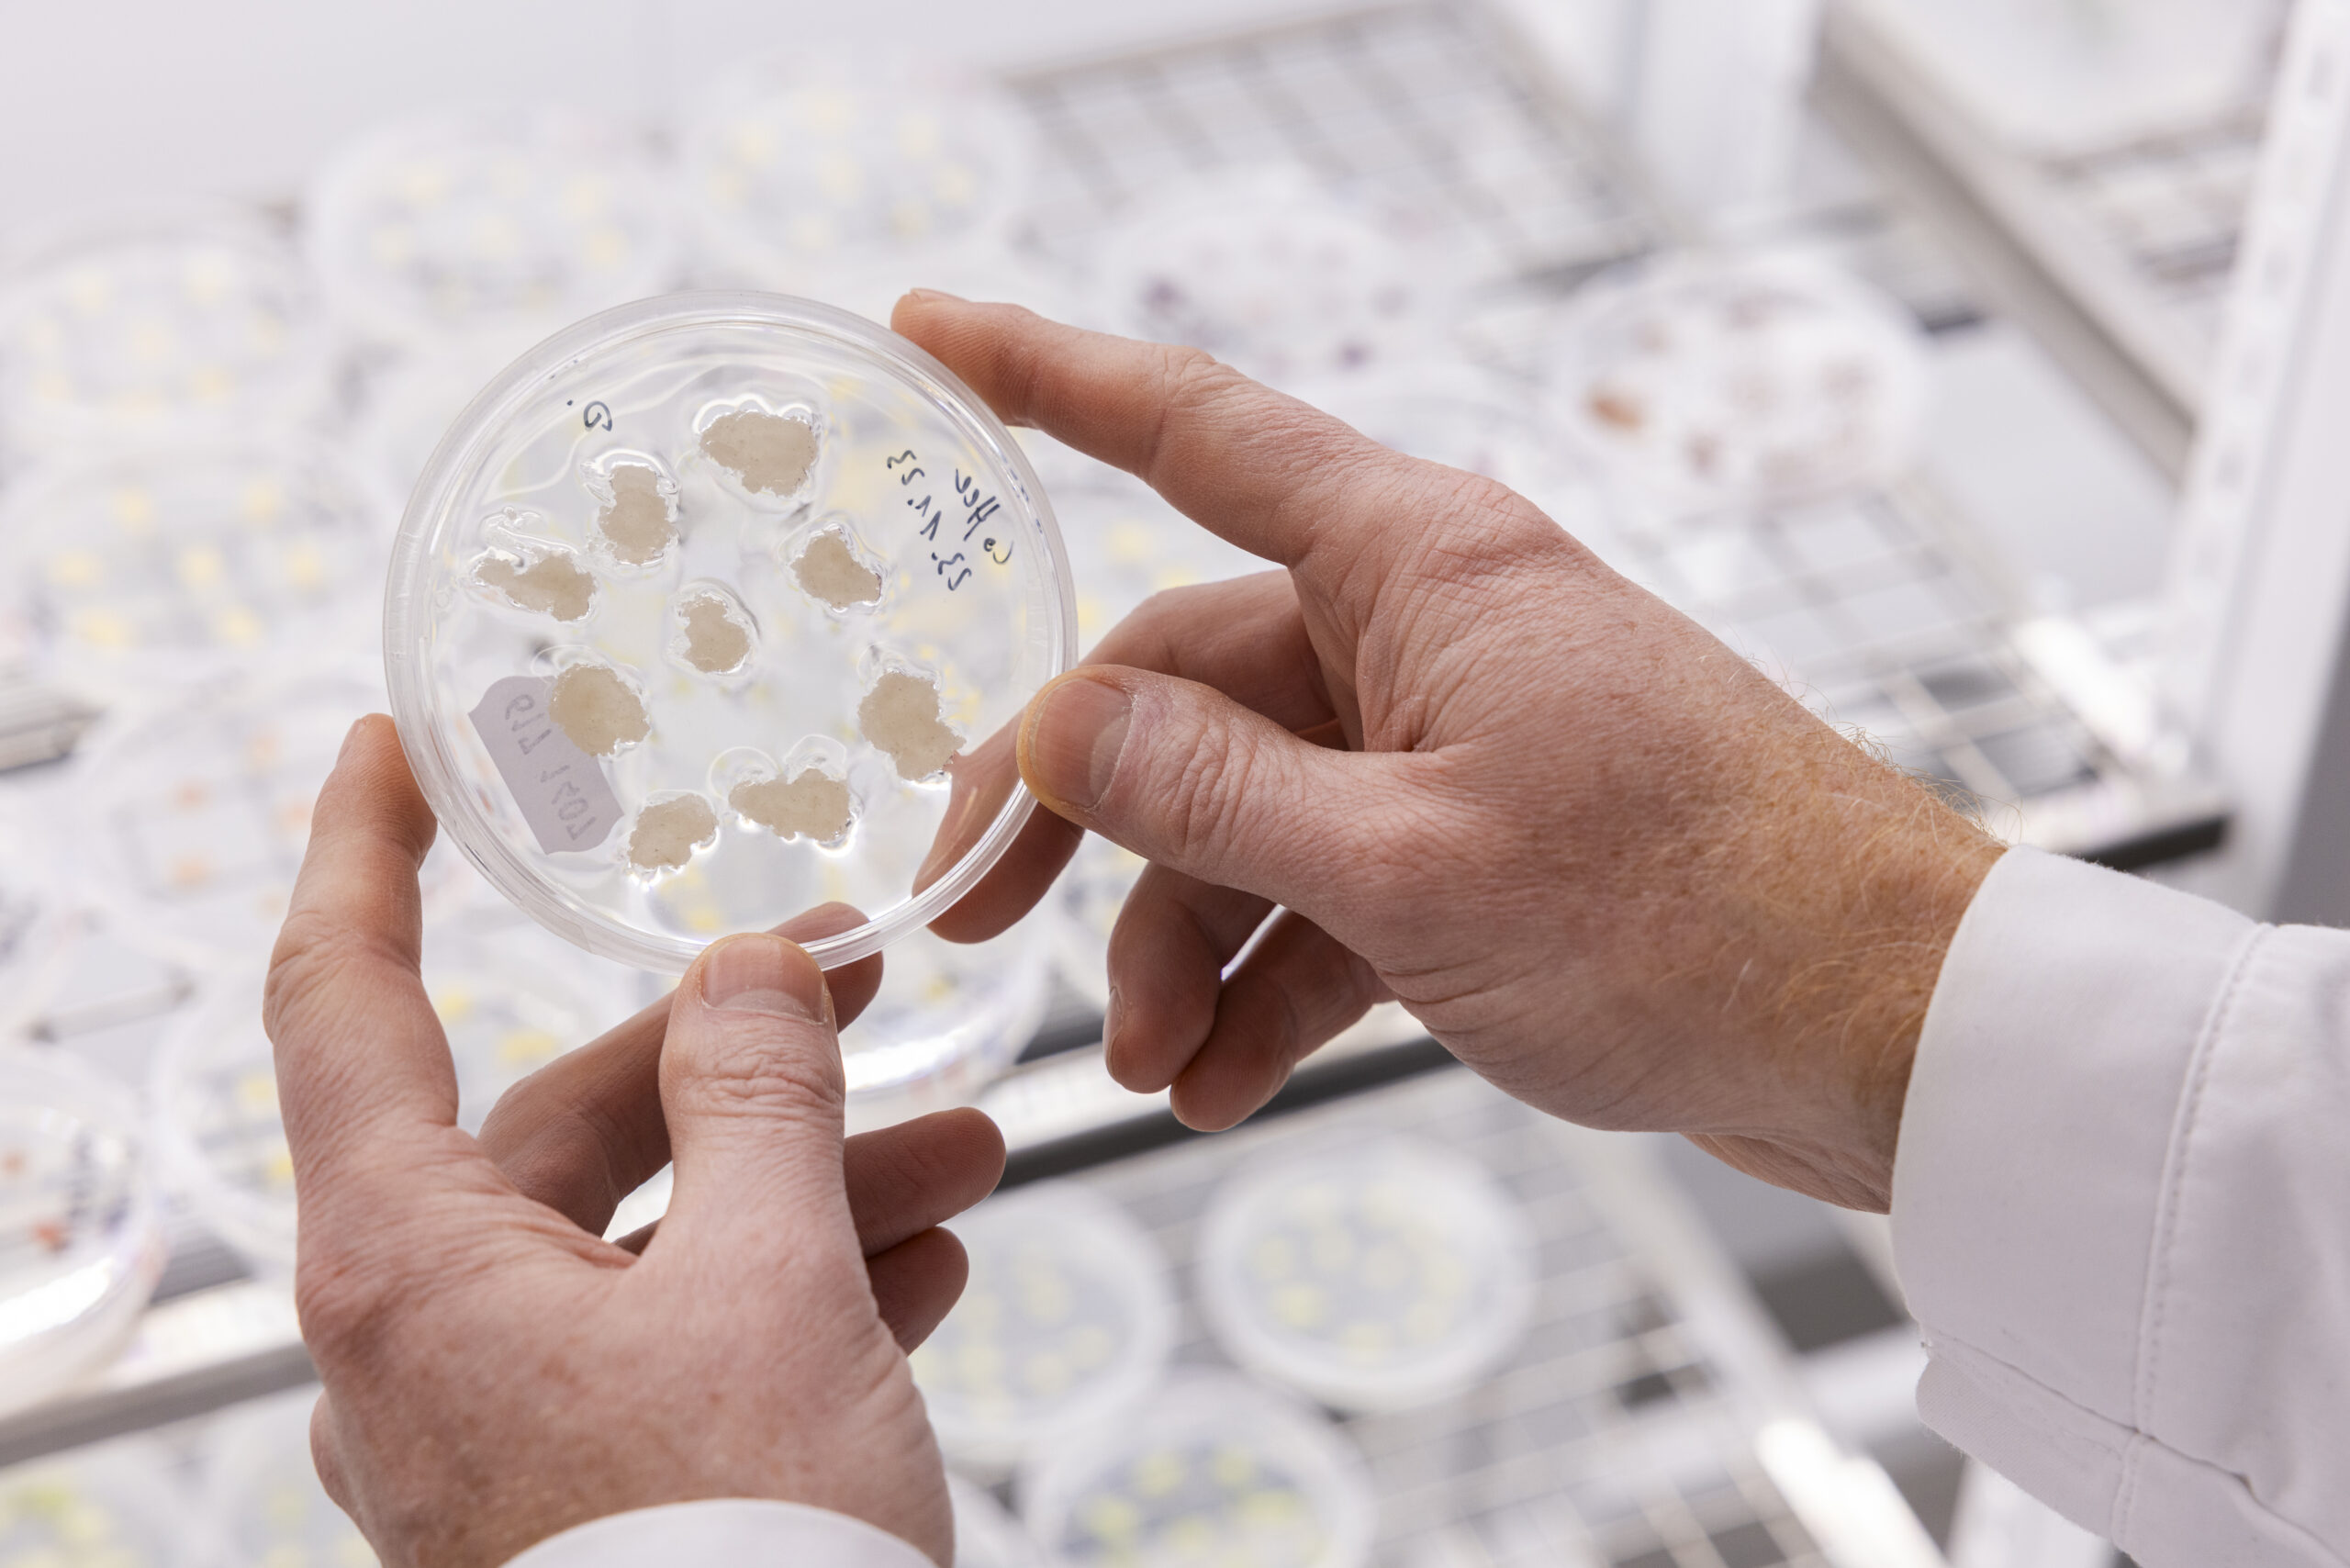

Foto: Graciela Zavala / Rainforest Alliance
20. November 2025
Nachhaltiger Kick! – Wach werden & Welt retten durch achtsamen Kaffeekonsum
Ein Feature von Fiona Schrafl
„Kaffee dehydriert den Körper nicht. Ich wäre sonst schon Staub.” Mit diesem Zitat spricht Franz Kafka humorvoll eine Wahrheit an: Für viele ist Kaffee mehr als ein Getränk. Ein tägliches Ritual um den Tag zu überstehen. Koffein macht wacher, leistungsfähiger und fitter. Dabei stellt sich die Frage: Was kostet der morgendliche Wachmacher unserer Umwelt und Gesundheit? Die Kehrseite des Kaffeekonsums ist nicht so leicht verdaulich wie der erste Schluck am Morgen, denn Kaffeekonsum hat einige Schattenseiten, die es zu beleuchten gilt: vom Wasserverbrauch beim Anbau bis hin zum CO2-Abdruck.
Zahlen, die wachrütteln
Seit über 20 Jahren ist Kaffee das beliebteste Getränk der Deutschen. Mit einem jährlichen Pro-Kopf-Konsum von durchschnittlich 164 Litern zählt Deutschland fast konstant zu den Top 10 der weltweit meisten Kaffeetrinker. An der Spitze stehen durchweg skandinavische Länder, allen voran Finnland. Umso besser, dass explizit dort an nachhaltigeren Alternativen geforscht wird. Laut des jährlichen Reports „Kaffee in Zahlen“ von Statista, Tchibo und brand eins Wissen, trinken die Deutschen im Durchschnitt drei bis vier Tassen Kaffee täglich. Weltweit sind es Schätzungen zufolge über zwei Milliarden. Dabei stecken in einer einzigen Tasse bereits 140 Liter virtuelles Wasser. Dieser Begriff stammt vom britischen Wissenschaftler John Anthony Allan und beschreibt die Wassermenge, die zur Herstellung eines Produkts benötigt wird und somit „unsichtbar“ im Endprodukt enthalten ist.
Das Nutzen von Wasser ist per se nicht schädlich – weder für Mensch noch für Umwelt. Aber: „Die Auswirkungen des Exports von virtuellem Wasser hängen von regionalen Klimabedingungen und Produktionstechnologien in dem jeweiligen Erzeugerland ab“ , bestätigt eine Studie des WWF. Beispielsweise sei Brasilien, als Land mit der höchsten Menge an Anbau und Export von Kaffee, generell ein wasserreiches Land, habe aber ein enormes Problem mit Wasserverschmutzung und entsprechenden Folgen. Besonders problematisch ist die Nassverarbeitung von Kaffee, bei der die Kaffeebohnen mit Hilfe von Wasser von ihrem Fruchtfleisch getrennt werden, was zum einen viel Wasser verschlingt, und zum andern stark verschmutztes Abwasser hinterlässt, das klimaschädliches Methan freisetzt.
Der CO₂-Fußabdruck für 1 kg ungeröstete Bohnen liegt bei 4,82 kg CO₂-Äquivalenten – eine Maßeinheit, die die Klimawirkung verschiedener Treibhausgase auf die Wirkung von Kohlenstoffdioxid (CO₂) umrechnet. Von diesen Treibhausgasemissionen entfallen 58 % auf den Anbau, vor allem durch den Einsatz von Düngemitteln, die erhebliche Mengen an Lachgas freisetzen, das 298-mal klimaschädlicher ist als CO₂. Die Zubereitung verursacht mit 30 % den zweitgrößten Anteil, was auch Konsumenten alarmieren sollte. Überraschend ist, dass der weite Weg einer Kaffeebohne inklusive Röstprozess und Verpackung nur etwa 12 % ausmacht – umso wichtiger: eine Revolution im Anbau.
Aufbruch im Anbau
Diese Revolution lässt sich auf einen einfachen Nenner bringen: Mehr Schatten, weniger Wasser. Wie der Name schon verrät, sind Robusta-Bohnen widerstandsfähige Kaffeepflanzen, die 30–40 % des globalen Kaffeeanbaus ausmachen. Diese Bohnen werden vor allem in niederschlagsarmen und warmen Tieflandregionen angebaut. Sie sind die bitteren, koffeinhaltigeren „Schwestern” der bekannten Arabica-Bohnen und müssen häufig künstlich bewässert werden. Schattenbäume können die Notwendigkeit von Bewässerung verringern, da sie die Verdunstung reduzieren. Durch Mischkulturen verbessert sich zudem die Bodenqualität und die Biodiversität mit mehr Insekten, die als natürliche Schädlingsbekämpfer dienen.
Um eine effizientere Wassernutzung zu ermöglichen, können Techniken wie Tröpfchenbewässerung und der Einsatz von smarten Technologien unterstützen. Regenwasser kann zudem gesammelt und aufbereitet werden. Das immer wiederkehrende Problem, an dem der Einsatz scheitert ist jedoch der Preis.
Rund 25 Millionen landwirtschaftliche Haushalte sind für 80% der globalen Kaffeeproduktion verantwortlich. Niedrige Kaffeepreise, wovon auch nur ein geringer Teil bei den Erzeugern ankommt bestimmen den Einsatz von Technik oder andere aufwändige Maßnahmen. Der Kaffeepreis war 2024 und 2025 so hoch wie lange nicht mehr, gleichzeitig steigen die Kosten für Arbeitskräfte, Düngermittel und Pestizide. Der Mangel an finanziellen Mitteln und die zunehmende Bedeutung des Nachhaltigkeitsaspekts setzen kleine Kaffeebauern weiter unter Druck. Weil erwachsene Arbeitskräfte zu teuer sind, müssen oft auch Kinder Kaffeebohnen pflücken. Im Kaffeeanbau würden Kinder weniger ausgebeutet als im Kakaoanbau, trotzdem seien Berichte über Missbrauch zahlreich. Es ist daher umso wichtiger, diesen Kindern eine sichere Lebensgrundlage und Einkommensquelle zu schaffen.
Von Fairtrade bis Bio: Zertifikate im Kaffeehandel
Gemeinnützige Organisationen und Unternehmen unterstützen durch ihre Projekte die Kaffeefarmer. Sie vermitteln Wissen, pflanzen Bäume, setzten Standards. Zahlreiche Zertifizierungsstellen versprechen den Bauern, bei Einhaltung aller vorgegebener Kriterien, eine Prämie. Beim Fairtrade-Siegel ist dieser Wert fest, bei der Rainforest Alliance zum Beispiel nicht, sondern marktgetrieben. Unabhängige Zertifizierungen und ihre Projekte fördern den Verzicht auf Pestizide und gewährleisten den Arbeitsschutz. Um sicherzustellen, dass die Anforderungen tatsächlich eingehalten werden, „unterliegt das System einem mehrstufigen Überwachungsprozess. Zusätzlich müssen zertifizierte Betriebe umfassende Dokumentationen vorlegen, um ihre Nachhaltigkeitsmaßnahmen nachzuweisen“, erklärt Dilara Celik von der 4C Association. Diese Initiative legt mit ihrem 4C – Common Code for the Coffee Community – Kodex die Basis für “Kaffee aus einer verantwortungsvoll geführten Lieferkette. Durch eine speziell entwickelte Lösung ermögliche 4C die Rückverfolgbarkeit von Kaffee bis zur Feldkoordinate, sodass nachgewiesen werden könne, dass er nicht aus entwaldeten Gebieten stammt. Damit biete 4C eine verlässliche Orientierung für alle, die nachhaltigen Kaffee kaufen möchten. Zertifizierungen bieten eine Orientierung. Ein Produkt kann auch ohne teure Zertifizierung gut für die Umwelt sein. Matthias Heyder, Geschäftsführer der Nürnberger Rösterei „Rösttrommel“ empfiehlt beim Einkauf den Händler direkt über die Herkunft des Produktes und den dortigen Umständen zu fragen.
Kaffeegeschmack ohne Weltreise
Während der Caro-Getreide-Kaffee bereits in den 1950er Jahren als günstigere Kaffee- Variante eingeführt wurde, argumentieren moderne Start-Ups mit dem Nachhaltigkeitsvorteil regionaler Zutaten: Zichorienwurzel, Roggen, Hafer, und Lupinen. Onno Franse, zuständig für Forschung und Entwicklung beim niederländischen Unternehmen „Northern Wonder“ berichtet von ihren Anfängen: „Zwei Jahre brauchten wir, um all die möglichen alternativen Zutaten zu evaluieren. Wir haben uns hunderte verschiedene Samen, Beeren, Blüten, Wurzeln und Getreide angesehen, geröstet und ungeröstet, und jeweils ein sensuelles Profil erstellt.“ [übersetzt] Das Vergleichen des jeweiligen Geschmacks, Geruchs, der Textur und visuellen Wahrnehmung zielte darauf ab, ein Profil zu entwickeln, das dem des traditionellen Kaffees am nächsten kommt. Am Ende ihrer von Franse bezeichneten „botanischen Reise“, veröffentlichte Northern Wonder einen Mix aus Lupine, Kichererbse, Gerstenmalz und Zichorie. Feige und schwarze Johannisbeere spenden zusätzliches Aroma. Während man beim Kauf von Northern Wonder zwischen einer koffeinhaltigen und koffeinfreien Version entscheiden kann, setzt „Loffee“ aus Stuttgart komplett auf die von Natur aus koffeinfreie Lupine.

Lupinenkaffee aus Stuttgart – Foto: Loffee
„Die Möglichkeit, künstliches Koffein zuzugeben, besteht, allerdings möchten wir keine Verwirrung bei unseren Kund*innen schaffen. Unser Produkt ist von Natur aus koffeinfrei, dies soll nicht durch ein weiteres Produkt verwässert werden“, bekräftigt Klara Riedlinger, Loffee-Brand Managerin. „Gerade bei Koffein ist es so, wie bei den meisten Lebensmitteln – die Dosis macht’s. In geringen Dosen profitiert man überwiegend von den Wirkungen – ab einer gewissen Dosis kehren sich die Wirkungen eher um. Die Grenze ist dabei individuell, von Mensch zu Mensch verschieden“ , so Diplom-Oecotrophologin Birgit Warnecke. Die beiden Loffee-Gründer Jan Fladung und Simon Raab lösen mit Ihrem Produkt auch ein Nachaltigkeitsproblem. Ihre Lupinen stammen zu 100% aus deutschem, biologischen Anbau. „Ab 2025 bauen endlich Landwirte direkt für uns die Lupinen an, was sowohl uns als auch den Landwirten Planungssicherheit gibt“, ergänzt Raab. Der Röstprozess von Lupinen unterscheidet sich zum Röstprozess von Kaffeebohnen vor allem hinsichtlich Dauer und Verschleiß. „Die Mühle nutzt etwas schneller ab, da Lupinen härter sind als Kaffee“, erläutert Raab.
Revolution im Labor
Unter der Leitung von Dr. Heiko Rischer entwickelte ein Team des VTT Technical Research Centre of Finland einen zellulären Kaffee, der im Bioreaktor wächst, anstatt auf weit entfernten Plantagen. „In unserem Fall haben wir mit Arabica-Kaffee gearbeitet“, erklärt Rischer, „Der Prozess beginnt mit der Sterilisation der Pflanzenteile, um mikrobielle Kontamination zu vermeiden. Anschließend werden diese auf ein – ebenfalls – steriles Nährmedium gesetzt, das aus Zucker und verschiedenen Mineralien – Salzen – besteht. Anders als traditionelle Kaffeepflanzen betreiben die Zellen keine Photosynthese, daher wird ihnen Zucker als Energieträger zugeführt. Im dunklen Stahltank des Bioreaktors entstehen dann Zellklumpen, die zu einer Zellsuspension weiterverarbeitet und in immer größeren Volumen skaliert werden können – bis zu 1000 Liter Biomasse sind möglich. Anders als tierische Zellen sind pflanzliche nach Aussage von Rischer „unsterblich“ und können über Jahre hinweg kultiviert werden, ohne erneut Pflanzenmaterial zu benötigen. Um den entstandenen Zellbrei als „Kaffee“ trinken zu können, muss er noch getrocknet und geröstet werden. Jedoch ist das Rösten von Pulver weitaus schwieriger als bei einer Bohne, denn laut dem Experten wirke die Bohne selbst wie ein kleiner Reaktor und behält somit die Aromastoffe. Im großen Stil möchten die Forscher nicht produzieren und auch nicht als Anbieter auf dem Markt anbieten: „Uns als Organisation geht es hauptsächlich darum, Impact zu erzeugen. Sprich, wenn letzten Endes die Industrie die Ideen aufnimmt und sie umsetzt, tatsächlich Produkte entwickelt, dann ist unsere Mission erfüllt.“ Laborfleisch wurde bereits akzeptiert und wird konsumiert, kleine Umfragen von Rischer deuten ebenfalls auf vielversprechendes Potential von Laborkaffee.
Laborkaffee entsteht – Foto: Vesa Kippola
Wertschöpfungskette-Ende: Der Konsument
Wer letztlich über die komplette Existenz eines Produkts entscheidet, egal ob Kaffeebohne, Getreide, Zelle oder auch allen Dingen außerhalb des Lebensmittelbereichs: der Konsument. Wenn wir keine nachhaltigen Produkte kaufen, haben diese keinen positiven Einfluss auf die Umwelt, denn dann wird der Prozess angewandt, der günstiger ist, das getrunken, was besser schmeckt und der Baum gefällt, der einer Kaffeepflanze im Weg steht.
Schon beim Kauf des Rohprodukts legen wir den Grundstein – kennen wir die Herkunft, was sind die Inhaltsstoffe oder trägt das Produkt ein Siegel? Gefolgt von der Wahl einer umweltfreundlichen Zubereitung und entsprechender Entsorgung anfallender Abfälle –Kafeesatz, Alukapseln, recycelfähige Kaffeemaschine – haben wir ein Drittel des CO₂- Fußabdrucks selbst in der Hand.